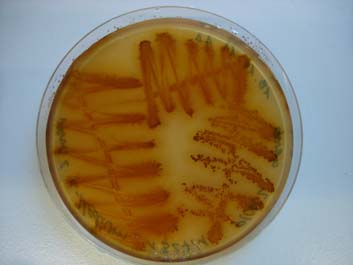

|
Lab Microbial Systems Ecology
|
||
Images of different organisms from our lab
| Tardigrada
For more information on Tardigrada, see e.g. the German Wikipedia link (contains more information than the English link), the Tardigrada newsletter); or enjoy a song about its fabulous life style The Tardigrada Song by Cosmo Sheldrake. |
|
    
|
|
|
|
|
| Lampropedia (in preparation) | |

|
|
| Novel Chloroflexi species (in preparation) | |
 |
|
|
|
|
| Metal transforming species (in preparation) | |
|
Click here to get back to the mainpage
* * * This site is currently under reconstruction * * *
This website works best with the explorer browser. Last updated on 3 April 2015. Lab Microbial Systems Ecology, Department of Microbiology, TUM, Germany, www.environmental-microbiology.de, contact info: nlee<at>environmental-microbiology.de
